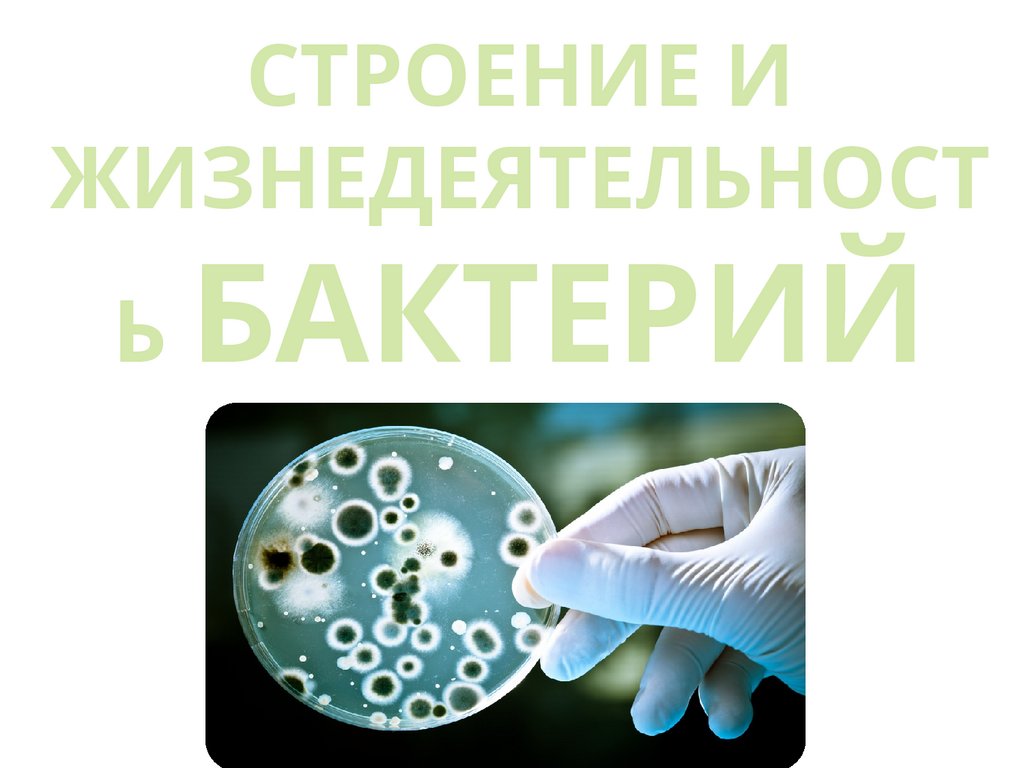

Похожие презентации:
Строение и жизнедеятельность бактерий
1. СТРОЕНИЕ И ЖИЗНЕДЕЯТЕЛЬНОСТЬ БАКТЕРИЙ
СТРОЕНИЕ ИЖИЗНЕДЕЯТЕЛЬНОСТ
Ь БАКТЕРИЙ
2.
Уровни клеточной организациипрокариоты
Бактери
Цианеи
и
Архебактерии
эукариоты
Растения
Животны
е
Грибы
3.
ГРУППАХАРАКТЕРИСТИКА
Архебактерии
Древнейшие бактерии (прим.
метанообразующие)
Эубактерии
Истинные бактерии, более
поздняя форма в
эволюционном отношении
Цианобактерии
(цианеи, сине
зеленые водоросли)
Фототорфные прокариоты,
выделяют кислород (как
растения)
4.
Впервые бактерий увидел воптический микроскоп и описал
голландский натуралист Антони
ван Левенгук в 1676 году. Как и
всех микроскопических существ
он назвал их «анималькули».
5.
Ввел термин «бактерии»Христиан Эренберг в 1828.
Луи Пастер в микробиолог,
иммунолог, создал
технологию пастеризации,
разработал метод
предупредительных
прививок;
6.
Роберт Кох открылтуберкулезную
палочку,
разработал
методы её
определения.
В 1905 он был
удостоен
Нобелевской
премии за
исследования
туберкулёза
7.
Изучениестроения
бактериальной
клетки началось
с изобретением
электронного
микроскопа в
1930-е.
Сканирующий электронный
микроскоп
8. 2) СИСТЕМАТИЧЕСКОЕ ПОЛОЖЕНИЕ:
относятся к прокариотам(доъядерным) организмам.
9. 3) СТРОЕНИЕ
1) НЕТ оформленного ядра;10.
2) Есть КОЛЬЦЕВАЯ ДНК, сбелками-гистонами НЕ связана.
НУКЛЕОИД – область
расположения ДНК в цитоплазме;
Набор генов – 1n
(гаплоидный),
тк хромосома одна!
11.
3) Клеточная стенка (оболочка)содержит гликопептид муреин;
У некоторых сверху есть слизистая
капсула (для защиты);
12.
4) По строению поверхностногоаппарата бактерии делятся на группы:
Грамотрицательные - есть тонкая
оболочка из муреина, которая защищена
внешней мембраной. При добавлении
красителя дает розовый или красный
цвет.
Грамположительные – только толстая
оболочка из муреина, окрашивается в
фиолетовый цвет.
13.
14.
5) НЕТ МЕМБРАННЫХ ОРГАНОИДОВ, ихфункции выполняют: впячивания
плазматической мембраны (мезосомы*), на
которых находятся дыхательные ферменты, для
синтеза АТФ;
Мелкие рибосомы (70S) – синтезируют белки;
*Ранее в ЕГЭ для впячивания
мембран использовали
термин «мезосомы», сейчас
так говорить нельзя, они
образуются только при
подготовке бактерий к
электронному
микроскопированию (в живой
бактерии их нет).
15.
6) Есть ворсинки, пили и фимбрии - дляприкрепления бактерий к субстрату или
другим клеткам, это места прикрепления
бактериофагов; Для передачи ген.
информации м\у бактериями;
16.
7) Есть плазмиды – маленькиевнехромосомные молекулы ДНК, которые
содержат гены, например, устойчивости к
антибиотикам, бактерии могут их передавать
друг другу;
17.
18. Изображения бактериальной клетки из заданий ЕГЭ:
19. В ходе эволюции у бактерий возникли внутренние впячивания мембраны - мезосомы. Объясните, какое значение имели мезосомы для
жизни организма.1) Увеличивается поверхность
мембраны клетки, что позволяет
усилить обмен веществ;
2) На мембранах увеличивается число
молекул ферментов, необходимых для
разных химических реакций;
3) Выполняют роль мембранных
органоидов.
20. Действие некоторых лекарственных препаратов связано с подавлением ферментативных процессов в клетках бактерий. Препараты
подавляютактивность ферментов, обеспечивающих
процесс окислительного
фосфорилирования. Синтез какого
вещества подавляют эти препараты? Где
происходят эти процессы в клетке
бактерии? Что произойдет с клетками
бактерий при действии этих препаратов?
21.
ОТВЕТ:1) препараты подавляют синтез молекул
АТФ;
2) процессы происходят на впячиваниях
плазматической мембраны клетки;
3) бактерии будут испытывать дефицит
энергии и погибнут (перестанут расти
и делиться).
22. Размеры
Размеры бактериальныхклеток колеблются в
пределах от 1 до 10-15 мкм
Клетки бактерий очень малы.
Сравните размеры бактерий
с толщиной человеческого волоса
23. Разнообразие внешнего строения бактериальных клеток
бациллы
кокки
Спиралевидные
24.
25. Кокки (шаровидная форма)
а) коккиб) диплококки
в) стрептококки (цепочки)
г) тетракокки
д) стафилококки (скопления «виноградные
гроздья»)
е) сарцины (3д – структуры)
26.
Диплококки
Кокки
Тетракокк
и
Стафилококи
Стрептококи
27. Кокки
диплококк
Кокки
стафилококк
сарцина
стрептококк
сарцина
стрептококк
стафилококк
28.
Бациллы(палочковидны
е)
• стрептобациллы
• диплобациллы
Являются
возбудителями
чумы, сибирской
язвы, столбняка,
брюшного тифа,
туберкулеза
29. Бациллы
бациллюсБациллы
клостридиу
м
кишечна
я
палочка
клостридиум
ботулинум
шигелла
протеус
псевдомонас
сальмонелла
30. СПИРАЛЕВИДНАЯ ФОРМА
Спириллы
Спирохеты
Вибрион
31.
Спирохеты(возбудители
Тифа и Сифилиса);
Treponema pallidum
возбудитель
сифилиса
32.
ВибрионыVibrio cholerae является
возбудителем холеры.
33.
1) ДЛЯ ПЕРЕНЕСЕНИЯНЕБЛАГОПРИЯТНЫХ УСЛОВИЙ
(недостатке пищи, влаги, резких
изменениях температуры) и
2) РАССЕЛЕНИЯ
34.
ОБРАЗОВАНИЕ СПОРЫЭтапы:
сжатие цитоплазмы вокруг кольцевой
ДНК → образование плотной оболочки.
35. 6)РАЗМНОЖЕНИЕ:
1. БЕСПОЛЫМ ПУТЁМ – делениемклетки надвое при помощи
перетяжек и перегородок (!митоза и
мейоза нет!). Этим процессам
предшествует репликация ДНК.
При благоприятных условиях
клетки делятся каждые 20 – 30
минут.
36.
37. 6)РАЗМНОЖЕНИЕ:
2. ПОЛОВОЙ ПРОЦЕСС(генетическая рекомбинация) –
БЕЗ образования гамет идет
обмен ген. информацией.
Есть 3 разновидности
конъюгация
трансдукция
трансформация
38.
КОНЪЮГАЦИЯТРАНСДУКЦИЯ
прямая
передача
участка ДНК
от одной
клетки
другой за
счет пилей и
фимбрий
перенос
фрагмента с
помощью
бактериофага
ТРАНСФОРМАЦИЯ
без контакта
клеток. Клеткареципиент
поглощает ген.
информацию
погибших
бактерий
39. По отношению к кислороду прокариоты делятся на три группы:
АЭРОБЫпотребляют кислород
для разложения
органических
веществ;
Энергию получают в
АНАЭРОБЫ
осуществляют гниение
и брожение (спиртовое,
молочно-,
маслянокислое) в
бескислородной среде;
ФАКУЛЬТАТИВНЫЕ
процессе дыхания. ФОРМЫ – могут жить в
обеих средах.
40.
8) МЕРЫ БОРЬБЫ И ПРОФИЛАКТИКИ ЗАРАЖЕНИЯМеры борьбы с бактериями
- Пастеризация (нагревании до 60-95 С) – погибают
сами бактерии;
- Стерилизация при 100С (нагревание, прокаливание,
кипячение мединструментов) – погибают бактерии и их
споры;
-Низкие температуры – снижают обмен веществ
бактерий, при заморозке создается безводная среда.
- Консервация сорбатами, нитритами – для защиты
продуктов питания;
- Дезинфекция химическими веществами (перекись
водорода, йод, марганцовка, спирт);
- Облучение ультрафиолетом помещений;
41.
42.
Меры профилактики заражения илечения человека бактериями
- Соблюдение правил личной гигиены;
- Антибиотики;
-Сыворотки (готовые антитела против
бактерий);
-Прививки (введение вакцины –
содержит ослабленные \ убитые
возбудители заболевания);
- Закаливание;
43.
44.
Что такое антибиотики, изчего их получают и где
1) Антибиотики – применяют?
вещества белковой природы,
выделяющиеся при жизнедеятельности клеток
плесневелых грибов (например пеницилла) или
бактерий;
2) Получают антибиотики с помощью метода
биотехнологии – микробиологическим синтезом. В
итоге специально выведенные штаммы
микроорганизмов проиизводят данное вещество;
3) Антибиотики используют при лечении
заболеваний, вызванных бактериями, так как именно
для них губительно действие этих веществ (ангина,
воспаление лёгких);
45.
Кто вызывает гниение и какпредохранить продукты
питания
от
гниения?
1) Гниение продуктов вызывают
гнилостные бактерии (по типу питания –
сапротрофы). Их активность и
размножение угнетают следующие
условия.
2) Низкая температура (заморозка) –
поэтому нужно хранить продукты в
холодильнике;
3) Отсутствие влаги, поэтому можно
«высушивать» некоторые продукты
(например грибы);
46.
4)Присутствие консервантов, например
уксусной кислоты – для маринования
овощей;
5) Хранение без доступа воздуха, в
герметичной посуде – большинству
бактерий для жизнедеятельности нужен
кислород, а без него они
погибнут.
47.
Для лечения бактериальных инфекций назначаютантибиотики, которые нарушают работу ферментов
бактерий, снижая их патогенные свойства. Иногда
врачи для лечения этих же заболеваний прописывают
лекарства, содержащие бактериофагов. В чем
преимущества приема препаратов с бактериофагами
по сравнению с антибиотиками? Почему врачи не
отказываются полностью от антибиотиков и
советуют чередовать их прием с приемом
препаратов, содержащих бактериофагов?
48.
1) действие антибиотиков уничтожает какпатогенные, так и полезные бактерии;
2) бактериофаги поражают строго определенные
клетки бактерий (действие вируса
специфично);
3) у человека вырабатываются антитела,
уничтожающие чужеродные белки
бактериофагов;
4) чередование антибиотиков и бактериофагов
препятствует выработке антител в организме
человека;
5) при длительном применении лекарств у
бактерий повышается к ним устойчивость;
6) чередование антибиотиков и бактериофагов
препятствует возникновению устойчивости
бактерий.
49.
9. ПИТАНИЕ БАКТЕРИЙА) Сапротрофы. Используют органические
вещества отмерших организмов (Молочно-,
уксусно-, маслянокислые бактерии);
1. ГЕТЕРОТРОФЫ
(источник пищи
– готовые
органич.
вещества)
Б) Паразиты. Используют органические
вещества живых организмов, вызывают
заболевания. (Возбудители чумы, холеры,
дизентерии, туберкулеза);
В) Симбионты. Взаимовыгодно сосуществуют с
другими организмами (Клубеньковые
(азотфиксирующие) бактерии на корнях Бобовых
растений);
2) АВТОТРОФЫ
(источник пищи
Г) Фототрофы. Источник энергии – солнечный
свет, углекислый газ и вода (Цианобактерии –
первые фотосинтезирующие организмы – см ниже
50.
ГЕТЕРОТРОФЫ(потребляют готовые органические вещества)
А) САПРОТРОФЫ
Используют
органические вещества
отмерших организмов
(Молочно-, уксусно-,
маслянокислые бактерии;
Болгарская и сенная
палочки);
В) СИМБИОНТЫ
Взаимовыгодно
сосуществуют с другими
организмами
(Клубеньковые
(азотфиксирующие) бактерии на
корнях Бобовых растений);
Б) ПАРАЗИТЫ
Используют органические вещества
живых организмов, вызывают
заболевания.
(Возбудители чумы, холеры, дизентерии,
туберкулеза);
51.
52. Азотфиксирующие бактерии на корнях бобовых растений
Бактерии переводятсвободный N2 атмосферы в
связанную форму нитратов
и нитритов NO2 и NO3 и
поставляют растениям.
53.
АВТОТРОФЫ(синтезируют органические вещества из
неорганических)
Г) ФОТОТРОФЫ
Д) ХЕМОТРОФЫ
Синтез веществ за счет
энергии солнечного
света с помощью
бактериохлорофилла
Источник энергии –
энергия окисления
неорганических веществ;
Цианобактерии
Нитрифицирующие,
азотфиксирующие,
железо-, серобактерии.
54. Роль бактерий
В МЕДИЦИНЕБактерии-паразиты – возбудители
инфекционных заболевания:
чума, холера, дифтерия,
дизентерия, туберкулез, сифилис,
проказа, столбняк, гонорея,
бруцеллез;
Получение вакцин;
55.
ХОЗЯЙСТВЕВ СЕЛЬСКОМ
Разлагают органические
удобрения до минеральных;
Силосование кормов
(молочнокислые бактерии);
Порча урожая, заболевания
животных и растений;
56.
Производство кисломолочныхВ ПРОМЫШЛЕННОСТИ
продуктов (сыр, сметана, кефир,
йогурт);
Закваска капусты, засолка огурцов и
помидоров;
Производство уксусной кислоты,
спиртов, ацетона;
Получение ферментов,
57.
В ПРИРОДЕРедуценты в пищевой цепи (бактерии
гниения превращают перегной в
минеральные вещества);
Клубеньковые (азотфиксирующие
бактерии) образуют симбиоз с бобовыми
растениями и помогают усваивать им
атмосферный азот;
Вступают в симбиоз: 1) в желудке
жвачных животных разлагают
целлюлозу; 2) в толстом кишечнике
млекопитающих помогают расщеплять
клетчатку, синтезируют витамины групп
К и В;
58.
В ряде случаев при вирусном заболевании(грипп или ОРВИ) врачи прописывают
антибиотики. Почему так делается? Надо ли
прописывать антибиотики при таких
заболеваниях? Ответ поясните.
1) при вирусном заболевании антибиотики
прописывать не надо,т.к. антибиотики
действуют только на бактерии, вирусы к
ним нечувствительны;
2) однако в ряде случаев возникают
осложнения бактериальной природы
(например, пневмония после гриппа), при
которых антибиотики прописываются;
59.
Лекарственный препарат содержитвещество цефиксим, ингибирующее синтез
пептидогликана, входящего в состав
клеточных стенок бактерий. Для лечения
каких заболеваний прописывают этот
препарат? Чем может быть опасно принятие
этого препарата без рекомендации врача?
1) препарат прописывают при заражении
организма бактериями (это антибиотик);
2) без рекомендации врача его принимать
нельзя, поскольку возможно формирование
устойчивости у бактерий (и переход
воспаления в хроническую форму);
60. ЦИАНОБАКТЕРИИ (СИНЕ-ЗЕЛЁНЫЕ ВОДОРОСЛИ)
61.
Нет жгутиков;Содержат пигменты: хлорофилл а, каротиноиды,
фикобилины;
Фотосинтез идет на внутрицитоплазматических
мембранных образованиях — хроматофорах;
Продукт фотосинтеза: гликопротеид,
откладывающийся в цитоплазме в виде зерен.
Могут вступать в симбиоз с: водорослями, мхами и
грибами (будут выполнять функцию хлоропалстов);
Размножение: деление надвое (у одноклеточных и
колоний), деление участков нитей (у нитчатых);
62.
А - осциллатория (Oscillatoria); Б - носток (Nostoc);В - анабена (Аnabaena); Г лингбия (Lyngbуа); Д - ривулярия (Rivularia); Е - глеокапса (G1eосарsа); Ж хроококк (Chroococcus); 1 - общий вид; 2 - вид при малом увеличениимикроскопа; 3 - отдельная нить при большом увеличении; 4 - гетероцисты
анабены
63.
Также фотосинтетическоефосфорилирование осуществляют,
зеленые и серные пурпурные
бактерии, но в качестве донора
электронов используют сероводород,
серу, сульфат, молекулярный водород
и т.д., но не воду. Поэтому в данном
случае молекулярного кислорода не
образуется.
64. ЗНАЧЕНИЕ ЦИАНОБАКТЕРИЙ В ПРИРОДЕ И КРУГОВОРОТЕ ВЕЩЕСТВ:
1) Поглощают СО2 из окружающей среды впроцессе фотосинтеза и обогащают О2 воду
и атмосферу;
2) Создают первичную продукцию для
экосистем (насыщают органическими
веществами воду и почву);
3) Фиксируют атмосферный азот (переводят
азот в соединения, доступные для других
организмов)
5) Являются звеном в цепи питания: служат
кормом для мелких рыб и животных.
65.
Найдите ошибки в приведенном тексте.Укажите номера предложений, в которых
они сделаны, исправьте их.
1. Цианобактерии (сине-зелёные) наиболее древние
организмы, их относят к прокариотам.
2. Клетки имеют толстую клеточную стенку.
3. У цианобактерий кольцевая хромосома обособлена
от цитоплазмы ядерной оболочкой.
4. У цианобактерий имеется хлорофилл, в их клетках
образуются органические вещества из
неорганических.
5. Фотосинтез у цианобактерий происходит в
хлоропластах.
6. В мелких рибосомах синтезируются белки.
7. Синтез АТФ происходит в митохондриях.
66.
ОТВЕТ: Ошибки в предложениях 3, 5, 7.3. У цианобактерий нет ядерной оболочки,
поэтому кольцевая хромосома ничем не
обособлена от цитоплазмы.
5. У цианобактерий нет мембранных
органоидов, в том числе хлоропластов, а
фотосинтез идет на выростах мембраны –
мезосомах;
7. У цианобактерий нет мембранных
органоидов, в том числе и митохондрий.
67. ПРИМЕРЫ ЗАДАНИЙ ИЗ ЛЕКЦИИ ТЕМА «БАКТЕРИИ»
68.
1) Выберите три верных ответа. Какиеобщие признаки характерны для
бактерий и грибов?
1, 3, 4
1) имеют клеточные стенки
2) имеют мембранные органоиды
3) могут быть редуцентами
4) имеют генетический материал в
виде ДНК
5) формируют плодовые тела
6) могут содержать муреин в оболочке
69.
2) Выберите три верных ответа. Какиехарактеристики относятся к бактериямсимбионтам, обитающим в толстом
кишечнике? 2, 3, 5
1)всасывают основное количество воды
2)питаются целлюлозой
3)синтезируют витамин К
4)подавляют всасывание ионов
кальция
5)борются с патогенными штаммами
6)имеют оформленное ядро в клетке
70.
3) Выберите три верных ответа.Характеристиками изображенного на
картинке организма являются:2, 4, 5
1) имеют капсид
2) имеют пили для контакта между
клетками
3) белок синтезируется в ЭПС
4) клетки имеют оболочку
5) содержат кольцевую хромосому
6) ДНК находится в ядре
71.
4) Выберите три верных ответа.Какие бактерии являются
паразитами?
1)палочка Коха
2)столбнячная палочка
3)кишечная палочка
4)холерный вибрион
5)сенная палочка
6)болгарская палочка
1, 2, 4
72.
5) Установите соответствие междухарактеристиками и формами жизни,
обозначенными на рисунке цифрами 1, 2
221121
А) способен кристаллизоваться
Б) состоит из ДНК и белкового капсида
В) размножается простым делением
Г) имеет кольцевую молекулу ДНК
Д) облигатный клеточный паразит
Е) может образовывать споры
73.
6) Установите последовательностьсистематических групп, начиная с
самого высокого ранга.
315264
1)Бактерии
2)Ностоковые
3)Прокариоты
4)Носток сливообразный
5)Цианобактерии
6)Носток
74.
7) Экспериментатор внес в прокипяченноеохлажденное молоко культуру молочнокислых
бактерий. Как изменятся в молоке спустя сутки
после начала эксперимента содержание лактата
(молочной кислоты) и лактозы (молочный
сахар)? Для каждой величины определите
соответствующее изменение:
1) увеличится
2) уменьшится
3) не изменится.
Запишите выбранные цифры для каждой величины.
Цифры в ответе могут повторяться
Содержание лактата
Содержание лактозы
12
75.
8) Выберите три верных ответа.Хемоавтотрофными организмами
являются:
1) азотфиксирующие бактерии
2) серобактерии
3) нитрифицирующие бактерии
4) кишечная палочка
5) водородные бактерии
235
6) вирус гриппа
76.
9) Установите соответствие междухарактеристиками и формами жизни, обозначенными на рисунке цифрами 1, 2
122211
А) является облигатным внутриклеточным
паразитом
Б) при неблагоприятном воздействии образует
споры
В) имеет нуклеоид
Г) мембрана образует впячивания для размещения
ферментов
Д) генетический аппарат представлен молекулами
ДНК или РНК
77.
10) Выберите три верных ответа.Для прокариот характерно:
1) могут являться хемоавтотрофами
2) запасают питательные вещества в
форме волютина
3) размножаются митозом
4) размножаются при помощи спор
5) содержат ЭПС и лизосомы
6) неблагоприятные условия
126
переносят в виде спор
78.
11) Выберите три верных ответа. Какиепризнаки используют для описания
клетки, изображенной на рисунке?
1) гаметы
2) митоз
3) нуклеоид
4) замкнутая ДНК
5) рибосомы
6) мейоз
345
79.
12) Выберите три верных ответа.Какие признаки характерны для
цианобактерий?
1)вызывают "цветение" воды
2)имеют спиралевидный хроматофор
3)являются редуцентами
4)встречаются в составе лишайников
5)являются прокариотическими
фототрофами
145
6)размножаются зооспорами
80.
13) Лекарственный препарат содержитфермент лизоцим, разрушающий связи в
молекуле муреина. На какую группу
возбудителей инфекционных заболеваний
действует этот препарат? Ответ поясните.
Почему при лечении заболеваний рта и
глотки этот препарат в таблетках необходимо
медленно рассасывать, а не проглатывать
целиком? Укажите две причины.
1) препарат действует на бактерии;
2) клеточная стенка бактерий состоит из муреина;
3) при рассасывании препарат действует местно (на
слизистую рта и глотки);
4) при проглатывании фермент попадает в желудочный
сок;
5) в желудочном соке фермент денатурирует ИЛИ
расщепляется пищеварительными ферментами.
81.
14) Исследователь изучал возможность продлить срок храненияохлажденной рыбы с использованием препаратов, содержащих
бактериофагов. Исследователь разделил 20 тушек потрошеной
радужной форели на две группы. Тушки одной группы он опускал в
раствор, содержащий различные штаммы бактериофагов. После
хранения рыбы в течение 7 суток при температуре +8°C
исследователь определил микробную обсемененность мяса рыбы.
Результаты представлены в таблице. Что представляют собой
бактериофаги? Объясните результаты эксперимента. При
хранении рыбы при комнатной температуре через сутки
начиналось ее гниение. Почему обработка раствором с
бактериофагами не позволила полностью предотвратить этот
процесс? Укажите не менее двух причин.
Вариант
Микробное число (количество бактерий\мл)
Опыт
20.000
Контроль
360.000
82.
1) бактериофаги - вирусы бактерий (прокариот);2) рыба, обработанная раствором бактериофагов,
содержала меньшее количество бактерий;
3) так как бактериофаги вызывали гибель бактерий;
4) некоторые бактерии могли быть устойчивы
(резистентны) к бактериофагам;
5) при комнатной температуре размножение бактерий
происходило активнее, чем размножение бактериофагов
ИЛИ концентрация бактериофагов в растворе была
слишком низкой (не позволила уничтожить все бактерий)
ИЛИ бактериофаги попали не на все ткани рыбы (только на
поверхность) ИЛИ гниение рыбы вызывали грибы (и
другие микроорганизмы).
83.
15) Экспериментатор решил определить влияние антибактериальногосредства, используемого для обработки ран, на рост колоний одного из
штаммов бактерии Staphylococcus aureus. Он пропитывал диски из
фильтровальной бумаги растворами этого средства в различной
концентрации и помещал диски на чашки Петри с бактериями. Через сутки
экспериментатор определял радиус зоны, свободной от бактерий, вокруг
диска (радиус зоны ингибирования). Результаты эксперимента приведены в
таблице. Раствор с какой концентрацией препарата, согласно
результатам исследования, будет оптимальным для применения?
Ответ поясните. Почему используемые ранее антибактериальные
средства со временем могут оказаться неэффективными?
Концентрация препарата,
Средний радиус зоны
%
ингибирования, см
1
0,45
4
0,91
6
1,34
10
1,54
84.
1) 10%; 2) при такой концентрации радиус зоныингибирования был наибольшим; ИЛИ
1) 5%; 2) такая концентрация оптимальна по
эффективности с учетом расхода препарата (снижает
себестоимость, экономически целесообразна);
3) у бактерий возникает резистентность
(устойчивость) к антибактериальным препаратам;
4) результат мутационной изменчивости.
85.
16) Экспериментатор определял влияние антибиотика эритромицина нарост бактерий одного из штаммов Micrococcus luteus. Известно, что
эритромицин способен связываться с большой субъединицей 70S
рибосомы. Разные количества антибиотика добавлялись в питательную
среду на чашки Петри, засеваемые одинаковым количеством бактерий.
Спустя 24 часа подсчитывалось количество выросших колоний бактерий на
чашках Петри. Результаты эксперимента приведены в таблице. Объясните,
почему эритромицин подавляет рост колоний бактерии. Вызывает ли
эритромицин такие же изменения в клетках человека?
Аргументируйте свой ответ.
Концентрация эритромицина,
Количество колоний
мкг\мл
1
80
10
40
30
20
60
2
100
0
86.
1) эритромицин, связываясь с бактериальнойрибосомой, нарушает синтез белка
(трансляцию);
2) клетки бактерий не могут расти и делиться;
3) эритромицин не действует таким образом
на клетки человека;
4) в клетках человека рибосомы 80S типа
(отсутствуют рибосомы бактериального типа).
87.
17) Бактерий поместили в растворы, состав которых благоприятен для ихжизнедеятельности, и перемешали. Через некоторое время бактерии в
пробирках перераспределились. В пробирке 1 находятся аэробы, в пробирке
2, в пробирке 3 – факультативные анаэробы. Почему основная часть
бактерий в пробирке 3 стремится к поверхности раствора, но при этом
такие бактерии могут быть найдены на всём протяжении среды?
Аргументируйте свой ответ.
88.
1) собираются в основном на поверхности раствора,так как там больше кислорода;
2) кислород используется факультативными
анаэробами для осуществления дыхания
(окислительного фосфорилирования);
3) окислительное фосфорилирование является более
энергетически выгодным, чем гликолиз (брожение);
4) бактерии могут быть найдены на всём протяжении
среды, так как могут осуществлять анаэробный
(бескислородный) обмен.
89.
18) В рубце жвачных животных обитают бактерии,например, Ruminococcus spp., Ruminobacter spp.,
Prevotella spp. Экспериментатор для исследования
пищеварения коров ввёл в их рацион кормовую добавку
в виде мочевины. Через месяц он взял у пяти коров
рубцовую жидкость и подсчитал количество
микроорганизмов в ней. Результаты эксперимента
отражены в таблице. Как изменится количество
бактерий в рубцовой жидкости, если вместо
мочевины ввести в рацион здорового животного
антибиотик? Объясните, как и почему в этом случае
изменится масса животного.
1) количество бактерий уменьшится;
2) масса животного уменьшится (прирост массы уменьшится);
3) антибиотики подавляют деление бактерий (убивают бактерии);
4) бактерии рубца обеспечивают переваривание клетчатки (корма);
5) при гибели бактерий уменьшится количество доступных
питательных веществ (снизится качество питания).
90.
19) Какие функции выполняют микроорганизмыв рубце жвачных животных? Приведите не менее
двух примеров. Почему добавление серы в
рацион привело к изменениям, показанным в
таблице?
91.
1. У животных отсутствует фермент, который расщепляетцеллюлозу в клеточных стенках растений.
2. Животные питаются растительной пищей.
3. Микроорганизмы в рубце — симбионты: способны
вырабатывать фермент, расщепляющий клетчатку в
клеточных стенках съедаемой пищи.
4. Микроорганизмы подвергают корм механической
обработке.
5. Микроорганизмы разрыхляют, измельчают корм.
6. Микроорганизмы образуют витамины.
7. Сера входит в состав аминокислот, белков. В рубце
именно ферменты (белки) выполняют функцию
расщепления целлюлозы.
92.
20) Экспериментатор решил изучить процессыжизнедеятельности золотистого стафилококка (Staphylococcus
aureus). Для этого он поместил в питательную среду
определенное количество живых бактерий и добавил
антибиотик ципрофлоксацин, в последующие дни он измерял
количество живых клеток. Результаты эксперимента
представлены на графике. Как и почему изменяется
количество живых клеток бактерий в эксперименте после
добавления антибиотика? Как изменится количество
живых клеток бактерий, если на пятый день вновь
добавить ципрофлоксацин в культуру, но в большей
концентрации, чем в начале эксперимента? Ответ
поясните.
93.
1) количество живых клеток бактерий последобавления антибиотика уменьшается, а потом
начинает расти;
2) большинство бактерий погибает под действием
антибиотика;
3) устойчивые к антибиотику бактерии начинают
размножаться;
4) количество живых бактериальных клеток после
повторного добавления ципрофлоксацина сначала
(незначительно) снизится, а затем продолжит расти;
5) большинство бактерий в культуре устойчивы к
ципрофлоксацину
94. ДОПОЛНИТЕЛЬНЫЕ ЗАДАНИЯ ПО БАКТЕРИЯМ ДЛЯ САМОПРОВЕРКИ
95. 2
Выберите представителяпрокариот:
1) Амёба
2) Холерный вибрион
3) Дрожжи
4) Возбудитель оспы
96. 3
Выберите представителянеклеточных форм жизни:
1) Кишечная палочка
2) инфузория
3) ВИЧ
4) хлорелла
97. 3
Выберите представителяэукариот:
1) Возбудитель гриппа
2) Возбудитель туберкулеза
3) Возбудитель малярии
4) Возбудитель чумы
98. 3
Какой признак характерен длябактерий?
1) Наличие рибосом
2) Наличие цитоплазмы
3) Наличие плазмид
4) Линейная ДНК расположена в
цитоплазме
99. 3
Чем растения отличаются отбактерий?
1) Наличием оболочки
2) Наличием мембраны
3) Наличие пластид
4) Наличие генетического
материала
100. 1
Важную роль в накоплениикислорода на земле сыграли:
1. Цианобактерии
2. Бациллы
3. Спириллы
4. Вибрионы
101. 2
Споры бактерий служат для:1. Размножения
2. Приспособления к
выживанию в
неблагоприятных условиях
3. Передвижения
4. Для питания
102. 3
Бактерии изогнутойформы(запятая) носят
названия
1.Кокки
2.Спириллы
3.Вибрионы
4. Бациллы
103. 1
Бактерии, питающиеся готовымиорганическими веществами и
неспособные самостоятельно
создавать органические
вещества, носят название
1. Гетеротрофы
2. Автотрофы
3. Симбионты
4. Травоядные
104. 4
Дезинфекция – это1. Заболевание растений
2.Тесная полезная взаимосвязь
между 2 организмами
3. Процесс превращения сахара в
молочную кислоту
4.Способ уничтожения бактерий
105. 1
Какое заболевание вызываетвирус?
1) Герпес
2) Аскаридоз
3) Столбняк
4) Холера
106. 1
Какое заболевание вызываетвирус?
1) Герпес
2) Аскаридоз
3) Столбняк
4) Холера
107. 121212
Установите соответствие междупризнаком и царством: 1) бактерии,
2) растения.
A) все представители доядерные
Б) все представители эукариоты
B) размножаются бинарным делением
Г) есть ткани и органы
Д) есть фото- и хемосинтетики
Е) содержат хромопласты
108.
109. 145
Известно, что бактерия туберкулёзная палочка —аэробный, микроскопический, болезнетворный
организм. Выберите из приведённого ниже текста
три утверждения, относящиеся к описанию
перечисленных выше признаков бактерии.
(1) Размеры туберкулёзной палочки составляют в длину
1–10 мкм, а в диаметре 0,2–0,6 мкм.
(2) Организм неподвижен и не способен образовывать
споры.
(3) При температуре выше 20 °C во влажном и тёмном
месте сохраняет жизнеспособность до 7 лет.
(4) Для своего развития организм нуждается в наличие
кислорода.
(5) Туберкулёзная палочка является паразитическим
организмом.
(6) В природе организм распространяется не только с
110.
111.
112. 345
Выберите три верных ответа из шестии запишите цифры, под которыми
они указаны. Сходство бактерий и
растений состоит в том, что они
1) прокариотические организмы
2) имеют оболочку из клетчатки
3) имеют клеточное строение
4) среди них имеются автотрофы
5) обладают раздражимостью
6) способны к вегетативному
размножению
113. 221211
Установите соответствие между бактериями и ихтрофической группой в экосистеме: к каждой
позиции, данной в первом столбце, подберите
соответствующую позицию из второго столбца.
БАКТЕРИИ
ТРОФИЧЕСКАЯ
А) сенная палочка
ГРУППА
Б) болгарская палочка
В) холерный вибрион
Г) бактерия брожения
Д) столбнячная палочка
1) паразиты
2) сапротрофы
114. 122213
Соотнесите объект и егосистематическую
122213
принадлежность:
1) Вирус
2) Бактерия
А) возбудитель гриппа
Б) возбудитель холеры
В) стафилококк
Г) сенная палочка
Д) возбудитель оспы
Е) дрожжи
3) Грибы
115. НУКЛЕОИД\ЯДЕРНОЕ ВЕЩЕСТВО\КОЛЬЦЕВАЯ ХРОМОСОМА
НУКЛЕОИД\ЯДЕРНОЕ ВЕЩЕСТВО\КОЛЬЦЕВАЯ ХРОМОСОМА
Рассмотрите рисунок «Строение
бактериальной клетки». Запишите
в ответе структуру бактерии,
обозначенную на рисунке знаком
вопроса.
116. 123
Известно, что бактерия холерный вибрион — анаробная,одноклеточная форма жизни, паразитический организм.
Выберите из приведённого текста три утверждения,
относящиеся к описанию перечисленных признаков
бактерии.
(1) Клетка — организм бактерии имеет изогнутую форму и
виде запятой.
(2) Бактерия обитает в тонком кишечнике человека,
вызывая отравление,
(3) Энергетический обмен в теле бактерии заканчивается
гликолизом.
(4) Размножается бесполым путем.
(5) В неблагоприятных условиях жизни преобразуется в
спору.
(6) Споры находятся в неактивном состоянии в течение
многих лет.
117. 136
Выберите три верных ответа из шести изапишите в таблицу цифры, под
которыми они указаны.
Прокариотическая клетка не имеет в
своём составе
1. Ядра
2. Цитоплазмы
3. Эндоплазматической сети
4. Плазматичекой мембраны
5. Рибосом
6. Пластид
118. 23113
Установите соответствие междубактериями и её значением в природе
и жизни человека.
119.
Ответ: 356120. 345
Выберите три варианта. Почемубактерии относят к прокариотам?
1) содержат в клетке ядро,
обособленное от цитоплазмы
2) состоят из множества разнообразных
клеток
3) имеют одну кольцевую ДНК
4) не имеют ЭПС, лизосом и вакуолей
5) не имеют обособленного от
цитоплазмы ядра
6) имеют цитоплазму и рибосомы
121. 156
Выберите три верных ответа из шестии запишите цифры, под которыми они
указаны.
У прокариотических клеток есть
1) нуклеоид с ДНК
2) настоящее ядро
3) аппарат Гольджи
4) гомологичные хромосомы
5) рибосомы
6) плазмалемма
122.
Лекарственный препаратнарушает целостность
муреиновой клеточной стенки,
таким образом разрушая клетки
бактерий. Можно ли с помощью
данного препарата вылечить
грипп или амёбную
дизентерию? Ответ поясните
123.
• 1) грипп вызывается вирусом, адизентерия – амёбами
(одноклеточными животными,
простейшими);
• 2) на них данный препарат
(антибиотик) не подействует,
поскольку они не имеют
клеточной стенки из муреина
124.
Человек, заболевшийхолерой, пожал руку соседу и
пообедал морепродуктами
(креветками и устрицами) с
коллегой. Кто из них мог
заразиться холерой от этого
человека? Почему вибрионы
холеры часто сравнивают со
стаей рыб?
125.
1) заражение холерным вибрионом чащевсего происходит через воду и пищевые
продукты (например, недоваренные
моллюски); также источником заражения
являются испражнения заболевшего
человека, поэтому сосед мог заразиться
только в том случае, если на руках человека
были следы его испражнений, а коллега —
только съев недоваренные моллюски (при
условии, что они содержали вибрион
холеры);
2) вибрион холеры очень активен, самый
«отличный бегун» из подвижных микробов,
передвигается за счёт движения жгутика.
126. Рассмотрите рисунок. Дайте название изображенным образования. Назовите тип взаимодействия между растением и бактериями.
Объясните, что даютдруг другу бактерии
и растение.
127.
1) Клубеньки с азотфиксирующимибактериями на корнях бобовых.
2) Симбиоз
3) Бактерии – переводят
атмосферный азот в доступные для
растений соединения.
Растения – отдают часть органики
бактериям.
128. Осуществление земляных работ при строительстве одного из объектов привело к вскрытию скотомогильника 100-летней давности.
Спустя некоторое время вданной местности был объявлен
карантин в связи с эпидемией
сибирской язвы, возбудителем
которой являются бактерии.
Как с точки зрения биологии можно
объяснить эту ситуацию?
129. 1) в скотомогильнике было захоронение животных, инфицированных сибирской язвой; 2) споры сохраняют длительное время
жизнеспособность,поэтому, попав в организм
человека
или скота, вызывают
заболевание сибирской язвой
130.
131.
А – прокариот: Кольцевая ДНК; Нетмембранных органоидов
Б – эукариот: Есть ядро, и др.
мембранные органоиды: стигма,
132.
ЧЕМ БАКТЕРИИ ОТЛИЧАЮТСЯ ОТОДНОКЛЕТОЧНЫХ
ВОДОРОСЛЕЙ?
1) У бактерий нет оформленного ядра, а у
водоросли есть.
2) Клеточная стенка бактерии состоит из
муреина, а у водорослей она из
целлюлозы.
3) У бактерии одна хромосома
кольцевидной формы, а у водоросли
несколько хромосом некольцевидной
формы.
4) У бактерий нет митохондрий, пластид,
аппарата Гольджи, ЭПС, лизосом.
133. НАЙДИТЕ ОШИБКИ В ТЕКСТЕ И ИСПРАВЬТЕ ИХ
134.
(1)Бактерии — прокариоты, наследственнаяинформация которых заключается в одной
линейной молекуле ДНК. (2)Все бактерии по
типу питания являются гетеротрофами.
(3)Азотфиксирующие бактерии обеспечивают
гниение органических остатков в почве. (4)К
группе азотфиксаторов относят клубеньковых
бактерий, поселяющихся на корнях бобовых
растений. (5)Нитрифицирующие бактерии
участвуют в круговороте азота. (6)Среди
паразитических бактерий хорошо известны
холерный вибрион, туберкулёзная палочка,
являющиеся возбудителями опасных
заболеваний человека. (7)Сапротрофные
бактерии питаются органическими остатками.
135.
ОШИБКИ ДОПУЩЕНЫ ВПРЕДЛОЖЕНИЯХ:
1) 1 — бактерии имеют замкнутую
(кольцевую) молекулу ДНК;
2) 2 — среди бактерий есть автотрофы;
3) 3 — азотфиксирующие бактерии
обеспечивают связывание
атмосферного азота и превращение
его в соединения, доступные для
использования высшими
растениями (питания высших
растений).
136.
1. Бактерии — это прокариоты,наследственное вещество их клеток не
отделено от цитоплазмы. 2. ДНК
бактерий представлена одной
молекулой, которая замкнута . 3.
Снаружи бактериальная клетка
окружена плотной мемраной из
муреина. 4. На рибосомах ее
гранулярной эндоплазматической
сети происходит биосинтез белка. 5.
При неблагоприятных условиях
бактерии размножаются с помощью
спор.
137.
Ошибки допущены в предложениях:3 — оболочка (а не мембрана)
содержит муреин
4 — эндоплазматическая сеть у
бактерий отсутствует:
5 — споры бактерий служат не для
размножения, а для переживания неблагоприятных условий.
138.
1. Бактерии-гниения относят к эукариотическим организмам. 2. Онивыполняют в природе санитарную
роль, т.к. минерализуют
органические остатки. 3. Эта группа
бактерий вступает в
симбиотическую связь с корнями
некоторых растений.
4. К бактериям также относят
простейших.
5. В благоприятных условиях
бактерии размножаются прямым
делением клетки.
139.
Ошибки допущены в предложениях:1) 1 — Бактерии гниения — это
прокариотические организмы.
2) 3 — Эта группа бактерий не живет
в симбиозе с другими
организмами.
3) 4 — Простейших относят
к одноклеточным
животным.
140. Лекарственный препарат связывается с малой субъединицей бактериальной рибосомы, блокируя её работу. При каких заболеваниях
назначают данныйпрепарат? Может ли он помочь при
аскаридозе? Ответ поясните.
1) препарат назначается при
бактериальной инфекции (это
антибиотик);
2) при аскаридозе он не поможет,
поскольку аскарида – эукариот, а
препарат блокирует работу только
прокариотической рибосомы
141. Почему лечение человека антибиотиками может привести к нарушению функции кишечника? Назовите не менее двух причин.
• антибиотики убивают полезныебактерии, обитающие в кишечнике
человека;
• нарушаются расщепление
клетчатки, всасывание воды и
другие процессы.
142.
Клетка организмакакого царства
изображена на
рисунке? Обоснуйте
свой ответ. Какие
структуры
обозначены цифрами
1-5? Какие функции
они выполняют?
143.
144. 20. Благодаря деятельности каких организмов скисает молоко? Почему у скисших молочных продуктов кислый вкус? 19. Какое молоко,
стерилизованное илисвеженадоенное, прокиснет
быстрее в одних и тех же
условиях? Ответ поясните.
145.
201) Молоко скисает в результате деятельности
молочнокислых бактерий;
2) В результате молочникислого брожения (на
стадии гликолиза – бескислородного этапа
энергетического обмена) образуется лактат
(молочная кислота), которая и способствует
появлению кислого вкуса.
19
1) Быстрее прокиснет свеженадоенное молоко,
так как в нём есть бактерии, вызывающие
сбраживание продукта.
2) При стерилизации молока клетки и споры
молочнокислых бактерий погибают, и молоко
сохраняется дольше.
146.
Исследователь решил изучить рост колоний только чтовыделенного штамма кишечной палочки на агаризованной
среде с ампициллином. Он посеял культуру кишечной палочки
на среды с разной концентрацией ампициллина – 0 мкг/мл, 10
мкг/мл и 100 мкг/мл, поставил в оптимальные для роста колоний
условия и на следующий день обнаружил, что на среде без
ампициллина выросло восемьдесят колоний, на среде с
концентрацией 10 мкг/мл выросло две колонии, на среде с
концентрацией 100 мкг/мл не выросло ни одной колонии.
Исследователь взял колонии, выросшие на концентрации 10
мкг/мл, и некоторое время выращивал их при этой
концентрации, после чего пересадил их на среду с
концентрацией ампициллина 100 мкг/мл и обнаружил, что
выросло шесть колоний. Какой параметр задаётся
экспериментатором (независимая переменная), а какой меняется
в зависимости от него (зависимая переменная)? Объясните,
почему при первом посеве на 100 мкг/мл ампициллина рост
колоний отсутствовал, а при последующем посеве – появился.
Объясните, почему не стоит прекращать приём антибиотиков
при первых признаках улучшения самочувствия пациента и
нужно принимать полный курс антибиотиков.
147.
1) независимая переменная – концентрацияампициллина, зависимая переменная –
количество колоний кишечной палочки;
2) при первом посеве на 100 мкг/мл ампициллина
рост колоний отсутствовал, так как для бактерий,
не имеющих механизмов защиты от данного
антибиотика, концентрация оказалась летальной;
3) при выращивании на среде с концентрацией
ампициллина 10 мкг/мл у бактерий выработалась
устойчивость к ампициллину, позволившая
переносить концентрацию 100 мкг/мл;
4) устойчивость возникает в результате мутаций;
5) если не завершить курс лечения антибиотиком,
то повышается вероятность возникновения

Биология
Биология








